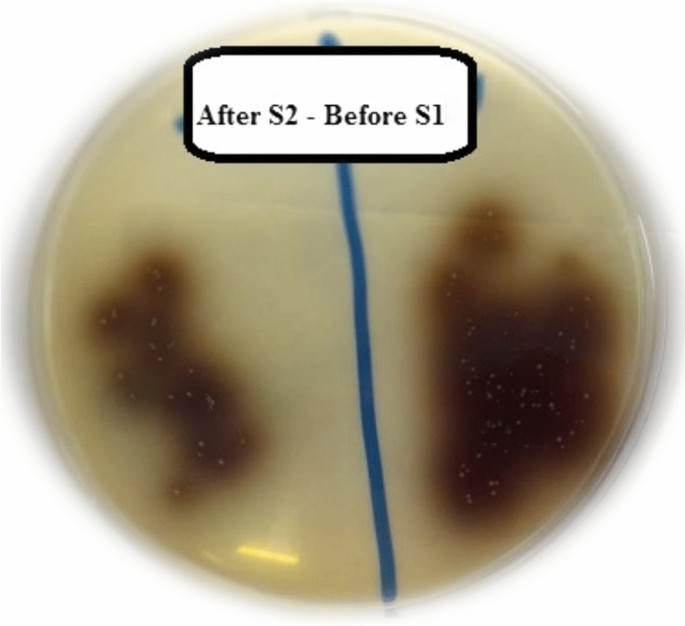

- Research
- Open access
- Published:
Evaluation of antibacterial effect of silver nanoparticles paste with and without curcumin as intracanal medication
Bulletin of the National Research Centre volume 46, Article number: 36 (2022)
Abstract
Background
The purpose of the current study was to compare the antibacterial activity of silver nanoparticles AgNPs paste and silver nanoparticles AgNPs with curcumin paste as intracanal medications versus calcium hydroxide Ca(OH)2 paste. Thirty extracted, human teeth with single roots were decoronated and mechanically prepared. After sterilization, roots were inoculated with Enterococcus faecalis for 10 days. Roots were separated into three groups in accordance to kind of intracanal medications used; Group A, silver nanoparticles AgNPs (Nanogate company, Cairo, Egypt). Group B, silver nanoparticles AgNPs with curcumin (Nanogate company, Cairo, Egypt). Group C, calcium hydroxide Ca(OH)2 (Metapaste, META BIOMED). First microbiological samples (S1) were collected from the canal, before insertion of intracanal medication. Intracanal medications were kept in root canals in all groups for 7 days; then second microbiological samples (S2) were collected from the canals after medicament removal. After the colony forming units CFUs have been counted, the data were statistically analyzed.
Results
In the three tested groups, the highest bacterial count was found in (S1), while the least bacterial count was found in (S2) with statistical significant difference between them.
Conclusions
The effect of AgNPs paste and AgNPs with curcumin paste was superior to Ca(OH)2 paste. AgNPs with curcumin paste had the best antibacterial effect.
Background
Achieving a successful endodontic treatment relies on several agents such as chemo-mechanical preparation, irrigation, intracanal medicaments, and optimum obturation (Paredes-Vieyra and Enriquez 2012). Chemo-mechanical preparation is an important step to eliminate the root canal infection during treatment (Siqueira et al. 2008). Instrumentation and irrigation are not sufficient for complete eradication of all remaining microbes in the spaces root canals due to its complexity and presence of resistant microorganisms such as Enterococcus Faecalis, which can revive under any conditions (Fabricius et al. 2006; Love 2001; Zehnder 2006). So, the utilization of intracanal medicaments is an substantial step to get rid of the remaining microorganisms (Chong and Pittford 1992).
The most popular used intracanal medicament is calcium hydroxide Ca(OH)2 due to Its high pH 12.5, which has an eradicative effect on proteins structure and cell membrane of the microorganisms (Spangberg et al. 1994), but there is several microorganisms that are resistant to it such as Enterococcus faecalis which withstand the vigor of Ca(OH)2 by liberation proton pump which decrease the internal pH of the cell (Haapasalo and Ørstavik 1987).
Recent studies (Ahn et al. 2009; Zhao et al. 2011) have converged on the benefits of nanoparticles to eradicate microorganisms from the canals. Silver nanoparticles AgNPs are an piognant broad spectrum antibacterial gadget that inhibits the oral bacterial growth. It has low toxicity as well as accelerates wound healing (Atiyeh et al. 2007; Tian et al. 2007).
Moreover, another study (Garg et al. 2014) focused on using natural products such as Curcumin instead of the commonly used medicaments as they have low cost and fewer side effects.
The active component of turmeric is curcumin, which is yellow in color. The underground stems of Curcuma longa is the source of curcumin. It is considered a medical herb for treatment of many diseases (Devaraj and Neelakantan 2014). It stops the growth and proliferation of many microorganisms as it has anti-inflammatory, antioxidant, and antimicrobial activities (Neelakantan et al. 2011; Moghadamtousi et al. 2014).
It is important to highlight on the role of silver nanoparticles AgNPs and curcumin as intracanal medicaments and their antibacterial efficacy. It is of scientific value to suppose the antibacterial effectiveness of silver nanoparticles AgNPs and curcumin as root intracanal medications and contrast them with the most popular root canal canal medicament, calcium hydroxide Ca(OH)2.
Methods
Three intracanal medicaments were used in this study
Silver nanoparticles AgNPs (Nanogate company, Cairo, Egypt), silver nanoparticles AgNPs with curcumin (Nanogate company, Cairo, Egypt), and calcium hydroxide Ca(OH)2 (Metapaste, META BIOMED).
Preparation of silver nanoparticles AgNPs and silver nanoparticles AgNPs with curcumin
Microwave irradiation was used for elaporation of silver nanoparticles AgNPs from silver nitrate (AgNO3) solution in ethanolic medium. polyvinylpyrrolidone PVP were used as a stabilizing gadget as reported by Pal et al. (2009). Ethanol worked as a lowering factor in the presence of microwave. To get the silver in powder form, the solvent was evaporated at mild temperature then, dilute the suspension with diluted carboxymethyl cellulose CMC aqueous paste 5% w/v (1 ml silver suspension + 4 ml CMC) to get 100 ppm semi-paste.
For curcumin loaded silver, 5 mg of curcumin was dispersed in 1 ml silver suspension before addition of CMC paste.
Characterization
Optical properties
Ocean Optics USB2000 + VIS–NIR Fiber optics spectrophotometer was used for obtaining of UV–Vis absorption spectra.
Shape and size
Transmission electron microscope TEM was executed on JEOL JEM-2100 standard resolution, and the accelerating voltage is 200 kV, respectively (Fig. 1a, b).
Properties
Tint | Yellow |
Creation | Semi-paste |
Optical properties (Abs.) | λmax ~ 405 nm |
Size (TEM) | 12 ± 3 nm |
Appearance (TEM) | Spherical shape |
Selection of the teeth
Thirty, extracted, human, single rooted teeth with mature apex were selected. They were taken from patients whom extract their teeth for orthodontic reason from National Research Centre Dental Clinic. The roots were examined for the absence of cracks, fractures, or resorption. The teeth were cleaned to remove any calculus deposits or soft tissue debris. They were conserved in normal saline solution. The anatomical crowns were sectioned at the cemento-enamel junction using tapered diamond stone on high-speed hand piece under water coolant. The roots lengths were adjusted to 14 mm (±) 1 mm root length.
Preparation of the roots
Mechanical preparation of the teeth
Working length for each root was determined by entering a size 15 K-file (Mani, Inc, Japan) to the root apex until it became out of the apex and then recouping 1 mm. The mechanical preparation were completed by REVO-S rotary system (RS; Micro-Mega SA, Besanḉon, France) mounted in micro-motor with a rotation speed 300 rpm and torque 2.5 N cm. Root canal treatment was done following the manufacture instruction; SC1 (Shaper and Cleaner 1), SC2 (Shaper and Cleaner 2), SU (Shaper Universal), AS30 (Apical Shaper 30), and AS35 (Apical Shaper 35) using in-and-out motion to full working length.
Irrigation protocol during mechanical preparation
One ml of 5% NaOCl was used between files. After instrumentation was finished, the roots were irrigated with 17% EDTA which was kept in each root for 3 min, then using 3 ml of 5% NaOCl. Each root was finally washed with 30 ml of sterile saline to eradicate the remaining solutions.
Closure of the apices of the canals
The out surfaces of the roots were covered with two strata of nail varnish, excluding the orifice opening and apical foramen. The apex was then closed with sterile pink wax.
Sterilization of the roots
Each root was individually placed in Eppendorf tubes. Each Eppendorf tube was placed in a separate sterilizing bag. They were autoclaved at 121 °C for 30 min (Fig. 2).
All of the following steps were done in the laminar air flow.
Preparation of microbial suspension
The inoculation suspensions of Enterococcus faecalis ATCC 4083 were standardized to 0.5 McFarland. Preparation of the microbial suspension was performed as follows; the microorganisms were cultured on Bile esculin agar plates. The colonies of the microorganism were picked up by a sterile bacteriological loop and emulsified in a sterile glass tube filled with 1 ml of sterile brain heart infusion BHI broth, then vortexed for thirty seconds. This preparation was repeated till the density of the microbial suspension was amended to be as a turbidity equal to 0.5 MacFarland.
Infection of the roots
The roots were placed in a sterile Eppendorf tubes separately. Each of the sterilized samples was inoculated with 10 μl inoculums of Enterococcus faecalis using a sterile syringe and then placed in centrifuge to ensure totally infection of the whole root canal. They were inserted into the incubator for 10 days at 37 °C. The media was altered after each 3 days (Fig. 3).
Premedication evaluation
After 10 days, first samples (S1) were taken from root canals using sterile paper point size 25. Paper point was inserted in root for 1 min, and then inserted into sterile Eppendorf tubes filled with 1 ml of BHI broth and vortexed for 30 s. Ten micron of each specimen was cultured on Bile esculin agar plates using sterile loop after serial dilution which was done to 1/1000 (Fig. 4). The plates were inserted into incubator at 37 °C for 1 day. Colonies were enumerated from the plates and then by using this equation (counting of colonies × amount of infected BHI broth × dilution) colony forming units CFUs /ml were calculated.
Placement of the medicaments in the canals
Samples were separated randomly to 3 groups according to kind of medicaments tested. Group A, silver nanoparticles AgNPs (Nanogate company, Cairo, Egypt). Group B, silver nanoparticles with curcumin (Nanogate company, Cairo, Egypt). Group C, calcium hydroxide Ca(OH)2 (Metapaste, META BIOMED). Silver nanoparticles AgNPs and silver nanoparticles AgNPs with curcumin were inserted to the canals by sterile plastic syringe. While the Ca(OH)2 paste was placed by the nozzle of the readymade injectable paste. The syringe or the nozzle was introduced into the root canal to a length shorter than the working length by 2 mm and slowly injected during withdrawal till the tested paste was shown at the orifice of the canal to ensure that the canals were completely filled. The access cavities were closed using sterile foil. The samples were reinserted inside the Eppendorf tubes and inserted into incubator at 37 °C for 7 days.
Removal of medicaments from canals
The medicaments were flushed out from the root canals after 7 days by irrigation with 5 ml of sterile normal saline using sterile disposable plastic syringe.
Post medication evaluation
After removal of the medicaments, the second samples (S2) were taken from the roots using sterile paper point size 25. They were cultured, incubated, and counted as the first samples.
Statistical analysis
In each group, the standard deviation and mean values were counted. The numbers of Enterococcus faecalis were changed to log10 values. The results were cheeked for its normal state by Shapiro–Wilk and Kolmogorov–Smirnov tests and reflect normal ranking. Paired sample t-test was used to contrast between two groups in relative samples. One-way ANOVA was used to contrast between more than two groups in non-relative samples. The significance level was presented at p ≤ 0.05. Statistical analysis was completed with IBM® SPSS® Statistics Windows Version 20.
Results
Relation between bacterial count before and after the insertion of intracanal medications
In the three tested groups, group A (Silver nanoparticles AgNps) (Fig. 5), group B (Silver nanoparticles AgNPs with Curcumin) (Fig. 6), and group C (Calcium Hydroxide Ca(OH)2) (Fig. 7); There was a statistically significant difference between Enterococcus faecalis count in the (S1) and (S2) groups where (p < 0.001) (Table 1).
The uppermost bacterial number was found in (S1) groups, while the lowermost bacterial count was documented in (S2) groups (Fig. 8).
Relation between groups in percentage of bacterial reduction
There was a statistically significant difference between silver nanoparticles AgNPs (Group A), silver nanoparticles AgNPs with curcumin (Group B) and Ca(OH)2 (Group C) where (p = 0.003).
A statistically significant difference was reported between Ca(OH)2 (Group C) and each of silver nanoparticles AgNPs (Group A) and silver nanoparticles AgNPs with curcumin (Group B) where (p = 0.007) and (p = 0.007), respectively (Table 2).
No statistically significant difference was reported between Silver nanoparticles AgNPs (Group A) and Silver nanoparticles AgNPs with curcumin (Group B) where (p = 0.999).
The uppermost bacterial reduction was reported in Silver nanoparticles AgNPs with curcumin (Group B) followed by Silver nanoparticles AgNPs (Group A), while the least bacterial reduction was found in Ca(OH)2 (Group C) (Fig. 9).
Discussion
The purpose of the current study was to compare the antibacterial activity of silver nanoparticles AgNPs paste, silver nanoparticles AgNPs with curcumin paste, and Ca(OH)2 paste. Enterococcus faecalis was chosen as the experiment microorganism as in spite of it is not the most common microorganisms in the root canal; it is isolated from 90% of cases with secondary infection (Sedgley et al. 2006; Figdor et al. 2003), and because of its resistance to high pH, high salt concentration, biofilm formation, and tolerance of starvation (Stuart et al. 2006; Portenier et al. 2003).
The microbiological steps of current study were performed under laminar air flow to prohibit contamination (Xinping et al. 2011). The medicaments were cleared from root canals using saline before taking the samples as it has no any antibacterial activity, consequently it does not influences the results of study (Schäfer and Bössmann 2005; Sharifian et al. 2008). Antimicrobial evaluation was done by using the colony forming units (CFUs) counting as it permits the gathering of the amount of living bacteria in the root canals (Cwikla et al. 2005).
The results of current study clarified that the decrease in bacterial count in the group treated with Silver nanoparticles AgNPs paste (group A) is higher than group medicated with Ca(OH)2 paste (group C) with significant difference after 7 days of intracanal medication application (Table 2). This could be due to overflow attraction of the molecules of bacterial cells with negative charge to silver that lead to inhibition the growth of bacteria and preventing the biofilm genesis (Bhardwaj et al. 2009). Silver nanoparticles AgNPs had the capability to interact with the thiol group of DNA molecule of bacteria, lead to its condensation and cell death (Castellano et al. 2007). It could be also related to the small size of silver nanoparticles AgNPs which was 12 nm, as smaller size affords more surface area. Therefore, more antibacterial effect (Guzman et al. 2012; Morones et al. 2005). The results were in agreement with Javidi et al. (2013) who proved that Ca(OH)2 single cannot kill E. faecalis completely after 1 week; while, adding silver nanoparticles to Ca(OH)2 can kill Enterococcus faecalis after 7 days. The results of our study were in agreement with Allakar (2010) who proved that nanoparticles had a capability to control the formation of bacterial biofilm and with Chamakura et al. (2011) and Guzman et al. (2012) whom stated that silver nanoparticles AgNPs had effective antibacterial activity even when used in low concentration. The results of this study were against the Mozayeni results (Mozayeni et al. 2014) that stated Nanosilver gel cannot be able to kill Enterococcus Faecalis. This may be due to the difference in manufacturing process, and the thick consistency of Nanosilver gel which may prevent the emission of nanoparticle ions.
The results of the current study stated that the decrease in bacterial count in the group treated with silver nanoparticles AgNPs with curcumin paste (group B) is higher than the group medicated with Ca(OH)2 paste (group C) with significant difference after 7 days of application (Fig. 9). This may be due to the antibacterial activity of curcumin against Enterococcus faecalis, as it restrains the cytokinesis of the bacteria through mobilization of filamentation. It also curbed the cytokinetic Z‑ring genesis in bacteria (Rai et al. 2008) and devastation of peptidoglycan cell wall of bacteria (Moghadamtousi et al. 2014). This was in line with the results of Vasudeva et al. (2017) and Prabhakar et al. (2013) whom stated that curcuma longa has antibacterial activity against Enterococcus faecalis and with Neelakantan et al. (2011) who proved that curcumin could get rid of Enterococcus faecalis biofilm after 2 days and 2 weeks. This result was against the results of Nosratzehi et al. (2019) who stated that curcumin has no antimicrobial effect; this may be due to using different microorganism as he used candida which was fungus not bacteria.
Silver nanoparticles AgNPs were used as vehicle for curcumin in group B, and the results showed more bacterial count reduction in this group than in silver nanoparticles AgNPs group (group A) with insignificant difference (Fig. 8). This may be due to combining of the antibacterial activity of silver nanoparticles AgNPs and curcumin. There was no other studies that assessed the antibacterial effect of this combination against Enterococcus faecalis, but this results were in accordance to the results of Chandra et al. (2017) who proved that silver nanoparticles AgNPs had a very good scope in their susceptibility to be utilized as a vehicle for other intracanal medication inverse resistant root canal bacteria.
In our study, the least bacterial reduction was found in group treated with Ca(OH)2 paste (Group C) in comparison to silver nanoparticles AgNPs paste (group A) and silver nanoparticles AgNPs with curcumin paste (group B) after 7 days of intracanal medication application (Table 1). This may be attributed to the thickness of dentin and bacterial biofilm which may lower the high alkalinity of Ca(OH)2. Therefore, decreasing its antibacterial effect (Sharifian et al. 2008; Evans et al. 2002). Also the antibacterial effect of Ca(OH)2 is relevant to emission of hydroxyl ions, thick paste consistency of Ca(OH)2 could not be suitable as medicament (Behnen et al. 2001). This results were in line with the research of Yadav et al. (2018) which proved that Ca(OH)2 intracanal medication cannot eradicate Enterococcus faecalis. This results disagree with the findings of Sjögren et al. (2018) which stated that application of Ca(OH)2 intracanal medication for 7 days can decrease the numbers of bacteria in root canals, this may be due to the difference in testing techniques and also that study was an old study published before discovering newer intracanal medication with more antibacterial effect.
Conclusions
(1) The antibacterial efficacy of silver nanoparticles AgNPs paste and silver nanoparticles AgNPs plus curcumin paste were better than Ca(OH)2 paste when used as root medication.
(2) Silver nanoparticles AgNPs with curcumin paste seem to be a perfect choice to defeat most resistant microorganisms from the root canals.
Availability of data and materials
The data generated or analyzed during this study are included within the article.
Abbreviations
- AgNPs:
-
Silver nanoparticles
- Ca(OH)2 :
-
Calcium hydroxide
- AgNO3 :
-
Silver nitrate
- PVP:
-
Polyvinylpyrrolidone
- CMC:
-
Carboxymethyl cellulose
- TEM:
-
Transmission electron microscope
- SC1:
-
Shaper and cleaner 1
- SC2:
-
Shaper and cleaner 2
- SU:
-
Shaper universal
- AS30:
-
Apical shaper 30
- AS35:
-
Apical shaper 35
- NaOCl:
-
Sodium hypochlorite
- EDTA:
-
Ethylenediaminetetraacetic acid
- E. Faecalis :
-
Enterococcus faecalis
- CFUs:
-
Colony forming units
- BHI Broth:
-
Brain heart infusion broth
- S1:
-
Sample 1
- S2:
-
Sample 2
References
Ahn SJ, Lee SJ, Kook JK, Lim BS (2009) Experimental antimicrobial orthodontic adhesives using nanofillers and silver nanoparticles. Dent Mater 25:206–213
Allakar RP (2010) The use of nanoparticles to control oral biofilm formation. J Dent Res 89:1175–1186
Atiyeh BS, Costagliola M, Hayek SN, Dibo SA (2007) Effect of silver on burn wound infection control and healing: review of the literature. Burns 33:139–148
Behnen MJ, West LA, Liewehr FR, Buxton TB, McPherson JC (2001) Antimicrobial activity of several calcium hydroxide preparations in root canal dentin. J Endod 27:765–767
Bhardwaj SB, Mehta M, Gauba K (2009) Nanotechnology: role in dental biofilms. Indian J Dent Res 20:511–513
Castellano JJ, Shafii SM, Ko F, Donate G, Wright TE, Mannari RJ (2007) Comparative evaluation of silver-containing antimicrobial dressings and drugs. Int Wound J 4:114–122
Chamakura K, Perez-Ballestero R, Luo Z, Bashir S, Liu J (2011) Comparison of bactericidal activities of silver nanoparticles with common chemical disinfectants. Colloids Surf B Biointerfaces 84:88–96
Chandra A, Yadav RK, Shakya VK, Luqman S, Yadav S (2017) Antimicrobial efficacy of silver nanoparticles with and without different antimicrobial agents against Enterococcus faecalis and Candida albicans. Dent Hypotheses 8:94–99
Chong BS, Pittford TR (1992) The role of intra canal medication in root canal treatment. Int Endod J 25:97–106
Cwikla SJ, Bélanger M, Giguère S, Progulske-Fox A, Vertucci FJ (2005) Dentinal tubule disinfection using three calcium hydroxide formulations. J Endod 31:50–52
Devaraj SD, Neelakantan P (2014) Curcumin-pharmacological actions and its role in dentistry. Asian J Pharmaceut Res Health Care 6:19–22
Evans M, Davies JK, Sundqvist G, Figdor D (2002) Mechanisms involved in the resistance of Enterococcus faecalis to calcium hydroxide. Int Endod J 35:221–228
Fabricius L, Dahlén G, Sundqvist G, Happonen RP, Möller AJ (2006) Influence of residual bacteria on periodical tissue healing after chemomechanical treatment and root filling of experimentally infected monkey teeth. Eur J Oral Sci 114:278–285
Figdor D, Davies JK, Sundqvist G (2003) Starvation survival, growth and recovery of Enterococcus faecalis in human serum. Oral Microbiol Immunol 18:234–239
Garg P, Tyagi SP, Sinha DJ, Singh UP, Malik V, Maccune ER (2014) Comparison of antimicrobial efficacy of propolis, Morinda citrifolia, Azadirachta indica, triphala, greentea polyphenols and 5.25% sodium hypochlorite against Enterococcus faecalis biofim. Saudi Endod J 4:122–127
Guzman M, Dille J, Godet S (2012) Synthesis and antibacterial activity of silver nanoparticles against gram-positive and gram-negative bacteria. Nanomedicine 8:37–45
Haapasalo M, Ørstavik D (1987) In vitro infection and disinfection of dentinal tubules. J Dent Res 66:1375–1379
Javidi M, Afkhami F, Zarei M, Ghazvini K, Rajabi O (2013) Efficacy of a combined nanoparticulate/calcium hydroxide root canal medication on elimination of Enterococcus faecalis. Aust Endod J 40:1–5
Love RM (2001) Enterococcus faecalis: a mechanism for its role in endodontic failure. Int Endod J 34:399–405
Moghadamtousi SZ, Kadir HA, Hassandarvish P, Tajik H, Abubakar S, Zandi K (2014) A review on antibacterial, antiviral, and antifungal activity of curcumin. Biomed Res Int 2014:186864
Morones JR, Elechiguerra JL, Camacho A, Holt K, Kouri JB, Ramírez JT (2005) The bactericidal effect of silver nanoparticles. Nanotechnology 16:2346
Mozayeni MA, Haeri A, Dianat O, Jafari AR (2014) Antimicrobial effects of four intra canal medicaments on Enterococcus Faecalis: an in vitro study. Iran Endod J 9:195–198
Neelakantan P, Subbarao C, Subbarao CV (2011) Analysis of antibacterial activity of curcumin against Enterococcus faecalis. Int J Curr Res Rev 3:37–42
Nosratzehi T, Nosratzehi M, Nosratzehi S, Lotfi F (2019) The comparison of the effect of curcumin with nystatin on inhibition level of Candida albicans. J Exp Pharmacol 11:93–97
Pal A, Shah S, Devi S (2009) Microwave-assisted synthesis of silver nanoparticles using ethanol as a reducing agent. Mater Chem Phys 114:530–532
Paredes-Vieyra J, Enriquez FJ (2012) Success rate of single-versus two-visit root canal treatment of teeth with apical periodontitis: a randomized controlled trial. J Endod 38:1164–1169
Portenier I, Waltimo TMT, Haapasalo M (2003) Enterococcus faecalis: The root canal survivor and “star” in post-treatment disease. Endod Top 6:135–139
Prabhakar AR, Swapnil T, Savita H, Sugandhan S (2013) Comparison of antibacterial efficacy of calcium hydroxide paste, 2% chlorhexidineg Gel and turmeric extract as an intra canal medicament and their effect on microhardness of root dentin: an in vitro study. IJCPD 3:171–177
Rai D, Singh JK, Roy N, Panda D (2008) Curcumin inhibits FtsZ assembly: an attractive mechanism for its antibacterial activity. Biochem J 410:147–155
Schäfer E, Bössmann K (2005) Antimicrobial efficacy of chlorhexidine and two calcium hydroxide formulations against Enterococcus faecalis. J Endod 31:53–56
Sedgley C, Nagel A, Dahlén G, Reit C, Molander A (2006) Real-time quantitative polymerase chain reaction and culture analyses of Enterococcus faecalis in root canals. J Endod 32:173–177
Sharifian MR, Shokouhinejad N, Aligholi M, Emaneini M, Arash K, Assadian H (2008) In vitro comparison of the effectiveness of chlorhexidine and two calcium hydroxide formulation on enterococcus faecalis. Iran End J 3:50–56
Siqueira JF Jr, Rôças IN, Riche FN, Provenzano JC (2008) Clinical outcome of the endodontic treatment of teeth with apical periodontitis using an antimicrobial protocol. Oral Surg Oral Med Oral Pathol Oral Radiol Endod 106:757–762
Sjögren U, Figdor D, Spangberg L, Sundqvist G (2018) The antimicrobial effect of calcium hydroxide as a short-term intra canal dressing. Int Endod J 24:119–125
Spangberg LSW (1994) Intracanal medication. In: Ingle JI, Backland LK (eds) Endodontics, 4th edn. Williams & Willkins, Baltimore, pp 627–640
Stuart CH, Schwartz SA, Beeson TJ, Owatz CB (2006) Enterococcus faecalis: Its role in root canal treatment failure and current concepts in retreatment. J Endod 32:93–98
Tian J, Wong KK, Ho CM, Lok CN, Yu WY, Che CM (2007) Topical delivery of silver nanoparticles promotes wound healing. Chem Med Chem 2:129–136
Vasudeva A, Sinha DJ, Tyagi SP, Singh NN, Garg P, Upadhyay D (2017) Disinfection of dentinal tubules with 2% chlorhexidine gel, calcium hydroxide and herbal intracanal medicaments against Enterococcus faecalis: an in-vitro study. Singap Dent J 38:39–44
Xinping L, Shengli L, Miaotao Z, Wenlong Z, Chuanghong L (2011) Evaluations of antibacterial activity and cytotoxicity on Ag nanoparticles. Rare Met Mater Eng 40:0209–0214
Yadav RK, Tikku AP, Chandra A, Verma P, Bains R, Bhoot H (2018) A comparative evaluation of the antimicrobial efficacy of calcium hydroxide, chlorhexidine gel, and a curcumin-based formulation against Enterococcus faecalis. Natl J Maxillofac Surg 9:52–55
Zehnder M (2006) Root canal irrigants. J Endod 32:389–398
Zhao L, Wang H, Huo K, Cui L, Zhang W, Ni H (2011) Antibacterial nano-structured titania coating incorporated with silver nanoparticles. Biomaterials 32:5706–5716
Acknowledgements
Not applicable.
Funding
The research was funded by the authors.
Author information
Authors and Affiliations
Contributions
SA and AM had contributed to the conception and design of the study. SA prepared the samples, performed microbiological tests of the study and wrote the manuscript. AM contributed to analysis and interpretation of data and revised the final presented manuscript. All authors read and approved the final manuscript.
Corresponding author
Ethics declarations
Ethics approval and consent to participate
The study was approved by Medical Research Ethics Committee of National Research Centre. Approval No: 2439102021.
Consent for publication
Not applicable.
Competing interests
The authors declare that they have no competing interests.
Additional information
Publisher's Note
Springer Nature remains neutral with regard to jurisdictional claims in published maps and institutional affiliations.
Rights and permissions
Open Access This article is licensed under a Creative Commons Attribution 4.0 International License, which permits use, sharing, adaptation, distribution and reproduction in any medium or format, as long as you give appropriate credit to the original author(s) and the source, provide a link to the Creative Commons licence, and indicate if changes were made. The images or other third party material in this article are included in the article's Creative Commons licence, unless indicated otherwise in a credit line to the material. If material is not included in the article's Creative Commons licence and your intended use is not permitted by statutory regulation or exceeds the permitted use, you will need to obtain permission directly from the copyright holder. To view a copy of this licence, visit http://creativecommons.org/licenses/by/4.0/.
About this article
Cite this article
Abdou, S.A., Mohamed, A.I. Evaluation of antibacterial effect of silver nanoparticles paste with and without curcumin as intracanal medication. Bull Natl Res Cent 46, 36 (2022). https://doi.org/10.1186/s42269-022-00723-1
Received:
Accepted:
Published:
DOI: https://doi.org/10.1186/s42269-022-00723-1